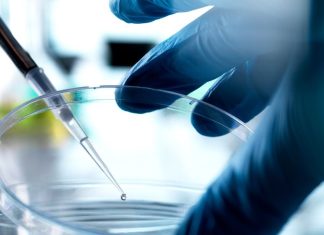
Зараз Флорида є притулком для неперевірених методів лікування стовбуровими клітинами

4 популярні товари Kirkland, припинені в Costco — як замінити їх дешево
Культові продукти Costco: коли улюблені товари зникають і як їх замінити Costco-це не просто оптовий магазин, це цілий феномен, що породжує лояльність і відданість....
Anthropic анулює доступ OpenAI до Claude
Ера ШІ: переосмислення правил гри в технологіях, бізнесі та суспільстві Останні місяці стали справжнім виром новин у сфері штучного інтелекту (ШІ). Від корпоративних баталій...
Tesla визнана частково відповідальною за загибель автопілота в 2019 році
Ціна автономності: як позов Tesla підкреслює ризики і недоліки автопілота Нещодавній позов проти Tesla, в якому компанія була визнана частково винною в аварії 2019...
Ціни на CD-диски Citi®: що потрібно знати, перш ніж відкривати їх
Інвестиції в майбутнє: все, що потрібно знати про CD-рахунки Citi і як максимізувати свій дохід У світі, де інфляція підкрадається непомітно, а ставки на...
Я на пенсії і шкодую, що чекав отримання соціального забезпечення до 75 років
Золото в старості: чому відкладати допомогу по соціальному забезпеченню довше 70 років-це помилка, про яку багато пенсіонерів шкодуютьІсторія Террі М. - це болісний урок...
Що, якби Фондовий ринок впав на 50% за один день?
Що, якби Фондовий ринок впав на 50% за один день? Аналіз наслідків та стратегії подоланняУявіть собі: ви прокидаєтеся вранці, відкриваєте новинний сайт, і бачите...
5 вживаних автомобілів класу Люкс, які є хорошою інвестицією для пенсіонерів
Вживаний Люкс для Золотого віку: як вибрати автомобіль, який інвестує у ваш спокійЗ настанням пенсійного віку багато хто переосмислює свої пріоритети. Фінансова стабільність, здоров'я...
Огляд Razer Pro Click V2 Vertical: Гібридна ігрова миша
Вертикальна революція в геймінгу: Razer Pro Click V2 Vertical-чи варто міняти звички?У світі геймінгу, де кожна мілісекунда має значення, а ергономіка часто відходить на...
4 найкращі складні телефони (2025), протестовані та переглянуті
Майбутнє в кишені: огляд найкращих складних телефонів 2025 року та вибір ідеальної моделіСкладні телефони-це вже не футуристична мрія, а реальність, яка стає все більш...
Повені в Техасі були передвістям того, що має статися
Повені в Техасі: дзеркало майбутнього для всієї країниТрагедія в окрузі Керр, Техас, стала не просто новинною історією про раптову повінь. Це-тривожний дзвінок, протверезний сигнал...
Вам потрібен ніж для барбекю?
Ера інновацій: як технології та матеріали переосмислюють Наш потреби в будинку та за його межамиСучасний світ диктує свої правила. Ми живемо в епоху, коли...
Зараз Флорида є притулком для неперевірених методів лікування стовбуровими клітинами
Епоха невизначеності: коли технології, Здоров'я та Свобода зливаються в хаосіМи живемо в дивовижний і водночас тривожний час. Технологічний прогрес, що обіцяє світле майбутнє, сусідить...
Це найкращий спальний мішок
Революція в кемпінгу: чому Rumpl Blanket Sleeping Bag змінив правила гри для сімейного відпочинкуЯк досвідчений мандрівник і мама, я знаю, що організація сну в...
Нова ера для WIRED-це починається з Вас
Епоха переосмислення: як WIRED та інші медіа виживуть в епоху ШІ та дезінформаціїМайбутнє медіа-питання, яке зараз хвилює всіх, хто працює в цій сфері, і,...
11 міст, в які пенсіонери, можливо, не захочуть переїжджати через почастішання ‘екстремальних погодних явищ’
Вибір місця виходу на пенсію: кліматичні ризики, про які варто задуматисяВихід на пенсію – це довгоочікуваний етап життя, час, коли можна присвятити себе улюбленим...